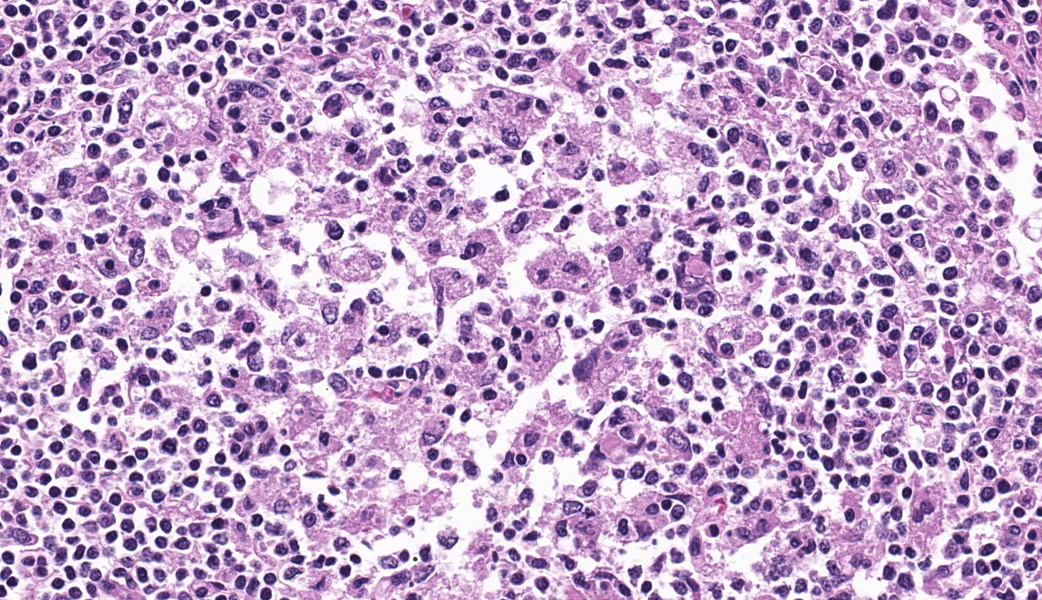

CASE II:
Signalment: Necropsy was performed on two male castrated pre-fattening pigs each of about 25 kg body weight (Sus scrofa domesticus).
History: The owner reported an increased mortality rate in a herd of pre-fattening pigs. Clinically affected animals showed yellowish to greyish, watery diarrhea with a sudden worsening of their general condition before they died spontaneously.
Gross Pathology: Both animals were in a moderate nutritional condition and showed severely sunk bulbi (dehydration). Multifocal to coalescing, yellowish, not removable plaques (fibrin) were observed on the mucosa of the stomach. The large intestine contained brown, fluid material and the mucosa of cecum and colon ascendens was multifocally to coalescing covered with yellowish, not removable plaques (fibrin/necrosis). The fibrin strands and necrotic areas were sometimes associated with the lymphatic tissue and band-like or sometimes appeared button-shaped. The rectum was empty.
Laboratory Results: The bacteriological examination (culture) revealed the following result: Salmonella entericasubsp. enterica serovar Typhimurium
Microscopic Description:Large intestine (Colon ascendens): Multifocal to coalescing, a thick layer of fibrin, sometimes intermingled with degenerated neutrophils, and abundant coccoid to rod-shaped bacteria are attached to the mucosa. In these areas, the mucosa is diffusely destroyed (necrosis) and replaced by fibrin, cell debris and fewer coccoid to rod-shaped bacteria. The lamina propria and the submucosa show a moderate infiltration with neutrophils as well as fewer lymphocytes and histiocytes. The few remaining crypts are dilated and some of them contain neutrophils and cell debris. Some capillaries and venules contain fibrin thrombi or are dilated and filled with neutrophils.
Mandibular lymph node: Lymphoid follicles are indistinct as a result of a severe lymphocyte depletion and replacement by aggregates of epithelioid macrophages with abundant eosinophilic cytoplasm.
Immunohistochemistry examination: Immunohistochemistry using an antibody directed against PCV-2 antigen revealed positive labeling in the cytoplasm of the epithelioid macrophages.
Contributor?s Morphologic Diagnoses: Large intestine: fibrinous to necrotizing enteritis, severe, chronic, multifocal to coalescing
Mandibular lymph node: granulomatous lymphadenitis, mild, multifocal, with lymphoid depletion
Contributor?s Comment: Salmonella spp. are gram-negative, aerobic or facultative anaerobic and motile bacteria. The route of bacterial entry is mostly fecal-oral. The bacteria are mainly detected in contaminated food, water and aerosols but flies and fomites can also act as transmission sources. Furthermore, transplacental infection is also possible. Salmonellosis is an important zoonotic disease and all known species are pathogenic. It is a significant cause of acute and chronic diarrhea and might even result in death of animals or humans. The most commonly isolated serovars in animals are Salmonella Typhimurium, Salmonella Enterica, Salmonella Dublin, Salmonella Choleraesuis and Salmonella Typhosa. Three forms of salmonellosis are reported: septicemic, acute enteric and chronic enteric. Which form occurs is depending on many factors such as infectious dose, previous exposure to the bacterium and stress (overcrowding, transport, cold temperatures, feed changes, pregnancy, parturition, surgery, anesthesia, antibiotic administration). It is possible that some of the recovered animals become carriers shedding the organism in their feces for at least 3-5 months.
Salmonella septicemia: The peracute Salmonella septicemia occurs in calves, foals and pigs and is mostly fatal. Younger animals get more frequently infected. This form of disease is usually caused by Salmonella Choleraesuis. Gross lesions are minimal or can present as fibrinous polyserositis and fibrinoid necrosis of blood vessels with microvascular thrombosis, which results in extensive petechiation and a blue discoloration of the extremities, ventrum, ears and tail in pigs due to endotoxemia. Furthermore, petechial hemorrhages can develop in many organs and tissues.
Acute enteric salmonellosis: The acute enteric form occurs in cattle, pigs, horses and rarely carnivores and is most frequently caused by Salmonella Typhimurium. A catarrhal enteritis with focal to diffuse fibrino-necrotic ileotyphlocolitis is the characteristic sign; the intestine is filled with mucus, fibrin, and occasionally blood. Moreover, multifocal hepatocellular necrosis, mesenteric lymphadenopathy and fibrinous cholecystitis are pathognomonic for the acute enteric salmonellosis.
Chronic enteric salmonellosis: The chronic form occurs in pigs, cattle and horses. Multiple necrotizing and ulcerated foci are commonly seen in the cecum, colon and rectum (?button ulcers?) of pigs. Rectal strictures can develop due to vascular thrombosis caused by the infection.
The co-infection with PCV-2 in this case is interpreted as an underlying disease leading to an immunosuppression and rendering the pigs more susceptible for secondary bacterial infection, in this case Salmonella enterica subsp. enterica Serovar typhimurium.
Contributing Institution:
Institute of Veterinary Pathology
Vetsuisse-Faculty (University of Zurich)
Winterthurerstrasse 268, CH-8057 Zurich
www.vetpathology.uzh.ch
JPC Morphologic Diagnosis:
- Colon: Colitis, necrotizing, subacute, diffuse, severe, with Peyer?s patch depletion and numerous coccobacilli.
- Lymph nodes: Lymphoid depletion, diffuse, severe.
JPC Comment:
What a fantastic case this is! It highlights some of the classic GI lesions in a severe case of salmonellosis, and the degree of lymphoid depletion present in both the GI-associated lymphoid tissue and the mandibular lymph nodes were excellent clues for the pathologist to suspect a primary cause of immune suppression as well. Many thanks to the contributor for providing this highly educational case to the WSC!
Due to the degree of necrosis and inflammationin the submitted section of colon. some participants had difficulty deciding in which segment of the GI tract this sample originated. The presence of occasional intact crypts and multiple lymphoid follicles were helpful in establishing an anatomic location of ?intestine? (remember, there are no lymphoid follicles in the stomach except in severe cases of Helicobacter spp infection in some species), but it can be challenging to get further than ?intestine? when a section is as inflamed and necrotic as the tissue is in this case.
There was discussion on the difference between lymphoid necrosis and lymphoid depletion, the former of which implies active targeting of lymphocytes while the latter can be an aftermath of lymphoid necrosis or can be a separate process secondary to any number of pathogeneses (i.e. SCID). The target cell for porcine circovirus-2 is macrophages, and a classic case of PCV-2 may result in granulomatous lymphadenitis, an unusual result of most viral infections. Lymphocytes are not directly targeted in the pathogenesis of PCV-2 but are rather secondary victims to the inflammation from immune response to the virus, making this case a great example of lymphoid depletion. This is further exacerbated in cases of secondary bacterial infection when the offending bacteria colonize Peyer?s patches, which is an important step in the pathogenesis of enteric salmonellosis.
Porcine circovirus-2 is a bit of a catch-all virus in that it causes a wide variety of clinical signs in affected pigs. It should always be on the differential list for sick pigs due to the many ways it manifests. PCV-2 is widely distributed in domestic pigs and wild boars, and has also been isolated from cattle, dogs, deer, chamois, mice, and various arthropods (i.e., ticks and mosquitoes). PCV-2 infection in swine can be either subclinical or cause numerous forms of illness that are collectively referred to as ?PCV-associated diseases? (PCVAD). These includes post-weaning multisystemic wasting syndrome (PMWS), porcine respiratory disease complex, porcine dermatitis and nephropathy syndrome, and both reproductive and enteric diseases.1 The immunosuppression associated with PCV-2 is characterized by lymphopenia, lymphoid cell (both B and T cell) depletion, and altered cytokine production.1 Because of its immunosuppressive effects, PCV-2 is frequently diagnosed concurrently with various other pathogens, and these combinations often provoke more severe disease together than they would individually, as seen in this case with concurrent salmonellosis.
During the initial phase of enteric Salmonella infection, the bacteria invades intestinal epithelial cells by employing an SPI-1 Type III secretion system (T3SS). This induces alterations in intestinal folds and in actin structures of the intestinal epithelial cells, facilitating the uptake of Salmonella by these non-phagocytic cells.4 Alternatively, Salmonella can invade M cells that cover Peyer's patches, enabling entry into lymphoid follicles.4 From here, the bacteria are taken up by phagocytes such as dendritic cells and macrophages. Upon internalization by these cells, Salmonella forms its own specialized membrane-bound blebs known as ?Salmonella-containing vacuoles? (SCVs). Once within these vacuoles, the expression of SPI-1 T3SS is down-regulated and the SPI-2 T3SS is up-regulated.4 Where the SPI-1 system facilitates entry into host cells, the SPI-2 system promotes survivability and replication of the bacteria within host cells. Within these vacuoles, the bacteria can also deliver various effector proteins into the cytoplasm of phagocytes, triggering caspase-1 activation and subsequent apoptosis.4 The lysis of these cells releases additional Salmonella bacteria into the host, further perpetuating infection.
Lastly, there was brief discussion during conference on host-adapted vs non-host-adapted Salmonella spp. and the histologic clues that may key the pathologist in to suspecting one versus the other - of course, morphology is not definitive, and culture and PCR are required for confirmation. That being said, the targeting of blood vessels is a feature seen most often with host-adapted Salmonella infections (S. cholerasuis and S. typhisuis in swine). This feature is not generally seen in non-host-adapted Salmonella infections (S. typhimurium, as in this case, does not target vessels, and causes a necrotizing enterocolitis, as it does in many other mammalian species). All Salmonella spp. in swine will target lymphoid tissues as part of their pathogenesis. Wrapping up this case discussion was a quick reminder of the orientation of porcine lymph nodes?remember, they are ?inside-out?; the medulla is on the outside!
References:
- Fehr E, Jakab F, Bonyai K. Mechanisms of circovirus immunosuppression and pathogenesis with a focus on porcine circovirus 2: a review. Vet Q. 2023;43(1):1-18.
- Jubb, Kennedy, Palmer`s. Pathology of Domestic Animals. Volume 2. Sixth edition. St. Louis, Elsevier; 2016.
- Zachary JF, McGavin MD. Pathologic Basis of Veterinary Disease. Fifth edition. St. Louis, MO:Elsevier Mosby; 2012.
- Zhang Y, Xu M, Guo Y, Chen L, Vongsangnak W, Xu Q, Lu L. Programmed cell death and Salmonella pathogenesis: an interactive overview. Front Microbiol. 2024;14:1333500.